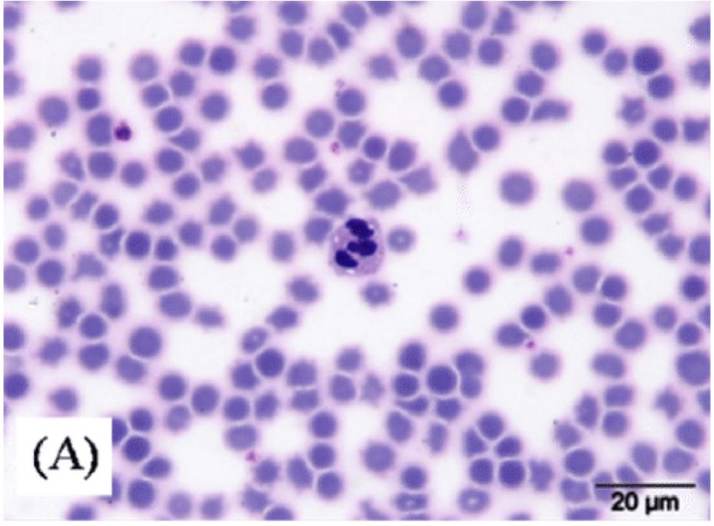

Pig Red Blood Cells
Cat.No.: CSC-C3102
Species: Pig
Source: Blood
Cell Type: Red Blood Cell
- Specification
- Background
- Scientific Data
- Q & A
- Customer Review
Porcine Red Blood Cells (pRBCs) are anucleate mature erythrocytes that are collected from the peripheral blood of the pig. These cells are 5-8 μm in diameter and have a biconcave disc shape. pRBCs use glycolysis as their source of energy and have a lifespan of 86-100 days. Hemoglobin of pRBCs is quite similar to human erythrocytes, however, the differences in blood group antigens (α-Gal) may cause immune rejection (e.g. hyperacute rejection), and transgenic modifications (knockout of GGTA1 gene) may be needed to enhance cell survival for xenotransfusion applications. When stored at 4 degrees Celsius, pRBCs are also susceptible to storage lesions (ATP depletion and lipid peroxidation), and can be a good model for pathological studies of blood preservation in transfusion medicine.
Applications of pRBCs in research settings include anemia mechanism studies, malaria infection models, evaluation of drug-induced hemolytic toxicity, and the development of artificial blood substitutes (hemoglobin-based oxygen carriers). The functions of oxygen transportation and aging of pRBCs, similar to human erythrocytes, are also used in microgravity studies on red blood cells in space biology research. Since porcine hematopoietic systems are highly conserved in human, pRBCs could be of clinical importance for xenotransplantation and blood replacement therapy in the future, though regulations of biosafety and animal ethics have to be strictly followed in their use.
Changes in the Levels of Hematological Parameters after pRBC Transfusion
Declining blood donation rates and narrow blood supply/demand ratios have introduced significant medical challenges. Genetically engineered pig red blood cells (pRBCs) have been evaluated as possible alternatives to human RBCs for transfusion and triple-gene knockout (TKO) modification has been shown to enhance compatibility between pRBCs and human blood in vitro. Here, Roh et al. examined the safety and efficacy of wild-type (WT) and TKO-pRBC transfusion in nonhuman primates (NHPs).
The hematologic profile of the prepared pRBCs is provided in Figure 1. Figure 2 illustrates the fold-change of each parameter versus baseline (D0pre). AUCs did not differ among groups except for MCH and monocytes: control MCH AUC was higher than that of transfusion groups and WT monocyte AUC was higher than control. RBC, HGB and HCT declined after phlebotomy, immediately rebounded post-transfusion (D0Tf) in transfusion groups, were unchanged in controls, and then continued to fall to a nadir on D3 and rebounded. Ratios at D0Tf and D1 were higher in transfusion groups than in control (Fig. 2); the D1→D3 decrease was greater in WT than in TKO. MCV and MCH decreased at D0Tf/D1 and then increased thereafter in transfusion groups, whereas there was minimal change in controls. RETA increased after bleed, peaked at D7, with no difference among groups. WBC and neutrophils increased transiently post-bleed then returned to baseline; monocytes increased intermittently only in transfusion groups, with WT D7 higher than control.


Effect of TKO/hCD55.hCD39 Pig RBC XTf on Complement Activation
Pig red blood cells (RBCs) are rapidly eliminated when transfused into non-human primates (NHPs) because of immune reactions involving antibody binding and complement activation. Kang et al. assessed the relationship between post-transfusion hemolysis and complement activation.
Transfusion RBCs were isolated from WT and genome-edited pigs. After withdrawing 25 % of blood, NHPs were transfused with WT (N=4), TKO (N=8), or TKO pig RBCs expressing human CD55/CD39 (TKO/hCD55.hCD39, N=4). In addition, four cohorts received repeated xenotransfusion (ReXTf, N=3), NHP autologous RBCs (N=3), or saline (N=4). Serial blood samples were collected for Hb, complement fragments (C3a, C4a, Bb), and agglutination titers. The effect of CD55 knockin on complement fragment levels in NHPs receiving TKO pig RBCs and TKO/hCD55.hCD39 pig RBCs was analyzed. Figure 3. Consistent with TKO-XTf, TKO/hCD55.hCD39-XTf increased C3a and Bb, but peak levels shifted to D3. At D3, ΔC3a and ΔBb in the TKO/hCD55.hCD39 group (0.20 [0.15–0.24] and 3.21 [2.60–4.11] µg/mL) were greater than TKO levels (0.03 [–0.01–0.06] and 0.45 [0.21–0.64] µg/mL; P=0.0065 and 0.0283).

50 mL of 0.2 mol/L phosphate buffer is mixed with 10 mL of 25% glutaraldehyde aqueous solution, and then double-distilled water is added to 100 mL.
Ask a Question
Average Rating: 5.0 | 1 Scientist has reviewed this product
Perfect
These cells are of high quality and allow reproducible results up to numerous passages.
12 Jan 2023
Ease of use
After sales services
Value for money
Write your own review


